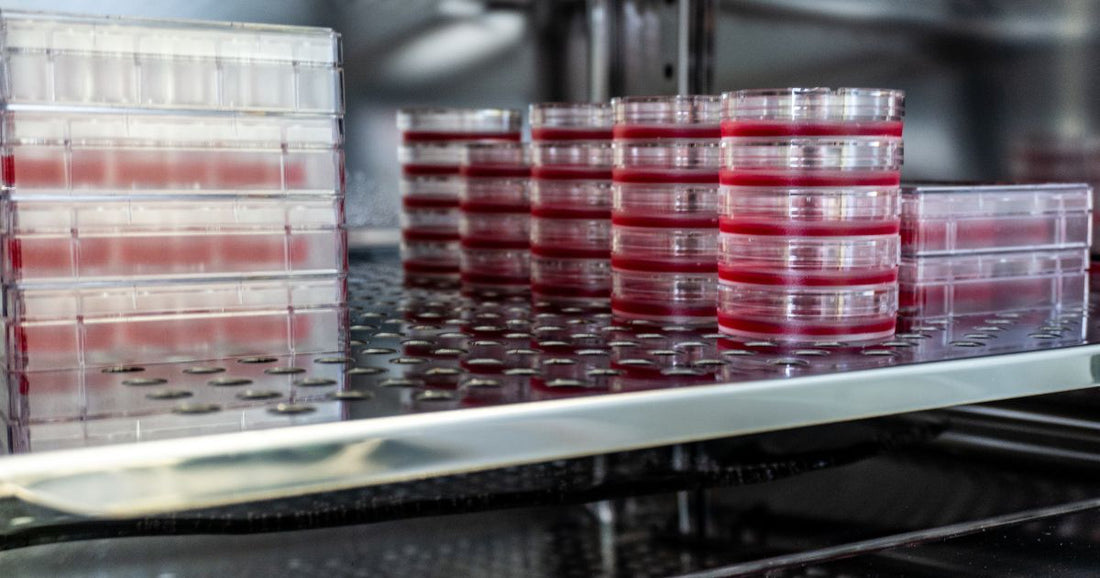
What is a CO2 Incubator? - CO2 Meter

CO2 incubators are enclosures designed to precisely control the environment needed to grow biological or cell cultures. While the term "incubator" is used in a broad range of applications like egg and poultry production, pharmacological and drug development, this article focuses on biological and cell incubation.
Typical laboratory and biological applications are required to maintain the same conditions in the incubator as inside the human body:
- 7.4 pH neutral
- 98.6°F (37°C)
- > 90% relative humidity
These three numbers create the optimal conditions for biological cell growth.
Life science and laboratory industries use CO2 sensors in biological incubators to provide stable growth environments. By controlling the CO2 and oxygen levels in incubators, technicians are able to maintain the correct pH in the growth cultures.
Control of temperature, humidity, pH, oxygen and CO2 in a sterile environment is critical for maximizing cell growth.
Why is CO2 needed in an incubator?
Humans are most comfortable at CO2 levels at or slightly above 400 ppm (0.04%). Which raises the question, why would a CO2 incubator that is used to grow tissue cultures need CO2 levels of 5 - 10%?
To keep culture cells under optimum conditions, the media they grow in needs to stay at neutral pH (around pH 7). The H2O in the cells can be turned into a carbonic acid (H2CO3) buffer by adding additional CO2. The combination of H2O and CO2 results in bicarbonate (HCO3-) and H2CO3 which keeps the pH neutral, and therefore has been found to affect the growth of biological cells the least. Here's a short video that explains the chemical reaction.
In other words, by adding additional CO2 at the right level you balance the Oxygen and prevent the pH inside the cells from becoming either alkaline or acidic, which both inhibit cell growth.
Maintaining CO2 Levels
CO2 levels inside a CO2 incubator are measured with accurate optical nondispersive infra-red (NDIR) sensors. There are two concerns when using an NDIR CO2 sensor:
- In high-altitude environments, the sensor readings must be adjusted to the change for barometric pressure.
- The sensor must be guarded against high humidity. Too much water in the air can result in condensation inside the CO2 sensor which will render the sensor inoperative.
CO2 Incubator Humidity Levels
While a water pan is often used to improve humidity, it creates potential problems with contamination and irregular humidity levels as the door is opened and closed. For that reason, an atomizer may be used to boost the humidity level along with a %RH sensor to control the humidity level.
CO2 Incubator Sterilization
Risks of contamination inside a CO2 incubator are primarily around cross contamination from fungi, viruses and bacteria. This can be controlled by conducting sterilizations between cycles. It is important that sterilization with heat or superheated water not come into direct contact with the CO2 sensor. For this reason, the CO2 sensor should be integrated into the incubator in such a way that it is not impacted by the sterilization cycle. This can be solved by:
- Gas sampling CO2 sensor (fixed or handheld) outside the incubator
- CO2 sensor with heat and moisture-resistant stainless-steel hood
Furthermore, scientists, researchers, and laboratory technicians will be able to ensure less handling and assembly errors with IR sensing because of the integrated temperature and pressure compensation. The IR technology in the MH-100 was designed to withstand high-temperature sterilization cycles up to 190°C (374°F), dramatically increasing the lifespan of the sensor. Competitors sensors do not offer this low maintenance and high temperature resilience.
It is important to understand when researching how an Infrared IR CO2 sensor works and its main advantages, that there are many different designs out there on the market. Comparing these sensors and understanding how each model affects accuracy, precision, or aggressive temperatures - should not be a rushed task.
The choice in selecting a sensing technology is also critical, because if the CO2 incubator is not operating properly or gases are not monitored efficiently cell growth, pH, and tissues can all be severely affected.
For years, incubator manufacturers and their end laboratory customers have worked to minimize altered effects and replicate their cell cultures natural environment to allow for optimal environmental conditions and results.
Limitations of CO2 Incubators
A growing field of study is the limitations of CO2 incubators as they relate to oxygen levels. Common sense would tell us that since living tissue like human cell cultures thrive in 20.9% oxygen-filled air, that this should be the desired oxygen level inside a cell incubator. Since ambient air is 20.9% oxygen, CO2 incubators need not be sealed from outside air.

The problem is that different living cell cultures grow at different oxygen levels. For example, while lung alveolar cells are exposed to 20.9% oxygen, the oxygen level in arterial blood falls to 10.5-13%. Many organs function normally at oxygen levels ranging from 2-8%. Logically, exposing every cell culture to the same 20.9% oxygen level would create a different environment than what they were exposed to inside the body, and hence, would change cell growth results.
The need to create anaerobic conditions for cell cultures includes a wide variety of applications including growing organ tissue parts, cancer diagnostics, genomic therapy, and virus and bacterium research for industrial, pharmaceutical and agricultural science.
To respond to this challenge, instead of using CO2 incubators scientists use sealed glove boxes with tri-gas CO2/O2/N2 incubation. The oxygen concentration is controlled by nitrogen and measured indirectly by measuring oxygen and carbon dioxide.
How does a CO2 Incubator Sensor Work?
Infrared (IR) sensors work by measuring the absorption relying heavily on the principle that each gas absorbs a distinct wavelength of light. Carbon Dioxide (CO2) absorbs the wavelength 4.3um within the infrared portion of the electromagnetic spectrum. An IR emitter then directs the infrared light through a sample of the growth chamber's atmosphere, then through an interferometer filter that isolates the proper wavelength and finally allows the sensor to process the data.
It is important to note, periodically calibrated circuits measure the amount of 4.3um light that strikes the sensor and calculates the difference between it and what was emitted by the source. The more CO2 in the gas sample the less light passes through, making the difference of allowing the circuits to calculate the accurate percentage of carbon dioxide.
Why choose an Infrared IR CO2 Sensor?
For those technicians working in incubation or microbiology labs, selecting the proper sensing technology can be a difficult task.
While additional sensing technologies are available in the field, Infrared IR CO2 sensors are the most highly sought after for a wide range of specified capabilities. The price difference between Infrared (IR) CO2 sensors and others such as thermal conductivity sensors is immense. Infrared sensors are much more cost-effective and affordable for technicians.
Additionally, the accuracy now available from an infrared sensor provides exceptionally precise data as compared to other sensor options.
Incubator CO2 Sensors
Maintaining a consistent level of CO2 in an incubator is critical. Not only is an accurate CO2 sensor required, but it must perform regardless of the temperature or humidity levels inside the device.
For example, the MicroSENS IR Incubator 0-20% CO2 Sensor has been optimized to measure 5% by volume of CO2 in cell incubators to manage ideal cell and tissue growth.
Unlike typical CO2 sensors, this sensor is designed to be resistant to heat and moisture. It can be permanently mounted inside the incubation chamber since it can withstand up to 190°C heat and steam sterilization. And because it can be calibrated in-place, it does not need to be returned to the factory for calibration. This minimizes down time between cell culture growth cycles.
NOTE: A new version of the MicroSENS IR Incubator sensor will be available in 2023 as a direct replacement for the Vaisala sensor line providing a more cost effective, accurate, and sterilization resistant sensor option. For more information click here.
Besides being cost-effective, accuracy and precision are other considerations to take in to account when selecting a sensor that is vital in medical industries. Those selecting an Infrared IR sensing technology will find that they are known to ensure reliable, consistent, and highly accurate measurements long-term. Whereas Thermal Conductivity (TC) sensing technologies have been known to exhibit issues in harsh humidity that often result in providing more unstable/inaccurate measurements and sometimes failure.
Another factor when researching Infrared IR CO2 Sensor for incubation is understanding that IR monitoring of carbon dioxide is most commonly preferred in laboratory environments that require high sanitization and hygiene practices. High temperature sterilization, sometimes with peroxide, will damage most IR sensors. Finding a sensor that can withstand these sterilization cycles is nearly impossible.
Other CO2 Sensor Options

When it is not cost-efficient to retrofit an old incubator with a dedicated CO2 Incubator sensor, other options are available.
CO2Meter has worked with several labs to integrate products like sensor development kits to continuously sample the atmosphere inside an incubator. The gas inside the incubator is routed through a flexible rubber tube between the door gaskets, run through a water trap to remove excess moisture, then pulled into the sensor using a micro-pump.
While not a built-in solution, it can easily be implemented and moved between several incubators to test the CO2 level from an exterior CO2 tank supply.
Scientists or laboratory technicians who also need to measure both oxygen and CO2 levels in a non-CO2 incubator environment use our GasLab® Pro Multi-Gas Sampling Data Logger.
This multi-gas detector is designed to simultaneously measure multiple gas concentrations through a sampling tube. Utilizing a micropump, the device draws samples into the sensing chambers, allowing each sensor to take a fast and accurate measurement of the sample. The sample can then be vented to air or returned to the incubator.
For more information on choosing the right monitoring solution for your application or for additional resources, contact us today.